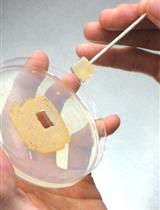
密苏里游动放线菌孢子的制备及其固体表面黏附力检测

往期刊物2019
卷册: 9, 期号: 24
生物化学
Semi-quantitative Determination of Protein Expression Using Immunohistochemistry Staining and Analysis: An Integrated Protocol
一种综合的实验方法:利用免疫组织化学染色和分析进行蛋白表达的半定量测定
细胞生物学
Analysis of EGF Receptor Endocytosis Using Fluorogen Activating Protein Tagged Receptor
利用荧光团激活蛋白标记受体分析EGF受体的内吞作用
免疫学
cDNA Display Mediated Immuno-PCR (cD-IPCR): A Novel PCR-based Antigen Detection Method
cDNA免疫PCR:一种新的基于PCR的抗原检测方法
Isolation and Stimulation of Peritoneal Macrophages with Apoptotic Jurkat Cells to Produce IL-10
提取和利用凋亡Jurkat细胞诱导腹腔巨噬细胞分泌白介素-10
Lysosome Targeting RedGreen-assay: Selective Autophagy Sensing Assay for Mammalian Cells
溶酶体靶向红绿试验
Propagation and Purification of Chlamydia trachomatis Serovar L2 Transformants and Mutants
沙眼衣原体血清型L2转化子和突变体的繁殖及纯化
微生物学
Protocol for Ribosome Profiling in Bacteria
细菌核糖体印迹测序方法
Preparation of Red Palm Weevil Rhynchophorus Ferrugineus (Olivier) (Coleoptera: Dryophthoridae) Germ-free Larvae for Host-gut Microbes Interaction Studies
用于宿主肠道微生物相互作用研究的红棕象甲(稻铁甲虫)(鞘翅目:椰象鼻虫科)无菌幼虫的制备
Preparation of Actinoplanes missouriensis Zoospores and Assay for Their Adherence to Solid Surfaces
密苏里游动放线菌孢子的制备及其固体表面黏附力检测
神经科学
Myelin Oligodendrocyte Glycoprotein 35-55 (MOG 35-55)-induced Experimental Autoimmune Encephalomyelitis: A Model of Chronic Multiple Sclerosis
髓鞘少突胶质细胞糖蛋白多肽( MOG35-55)诱发实验性自身免疫性脑脊髓炎:一种慢性多发性硬化模型
Semi-automated Model to Accurately Counting Sympathetic Nervous Fibers
交感神经纤维精确计数的半自动模型
植物科学
Analysis of Monosaccharides from Arabidopsis Seed Mucilage and Whole Seeds Using HPAEC-PAD
利用HPAEC-PAD进行拟南芥种子黏液和整粒种子中单糖的测定
干细胞
In vitro Differentiation of Human iPSC-derived Retinal Pigment Epithelium Cells (iPSC-RPE)
人诱导多功能干细胞来源的视网膜色素上皮细胞的体外分化
Retina Injury and Retina Tissue Preparation to Study Regeneration in Zebrafish
通过斑马鱼视网膜损伤和视网膜组织制备进行视力恢复研究